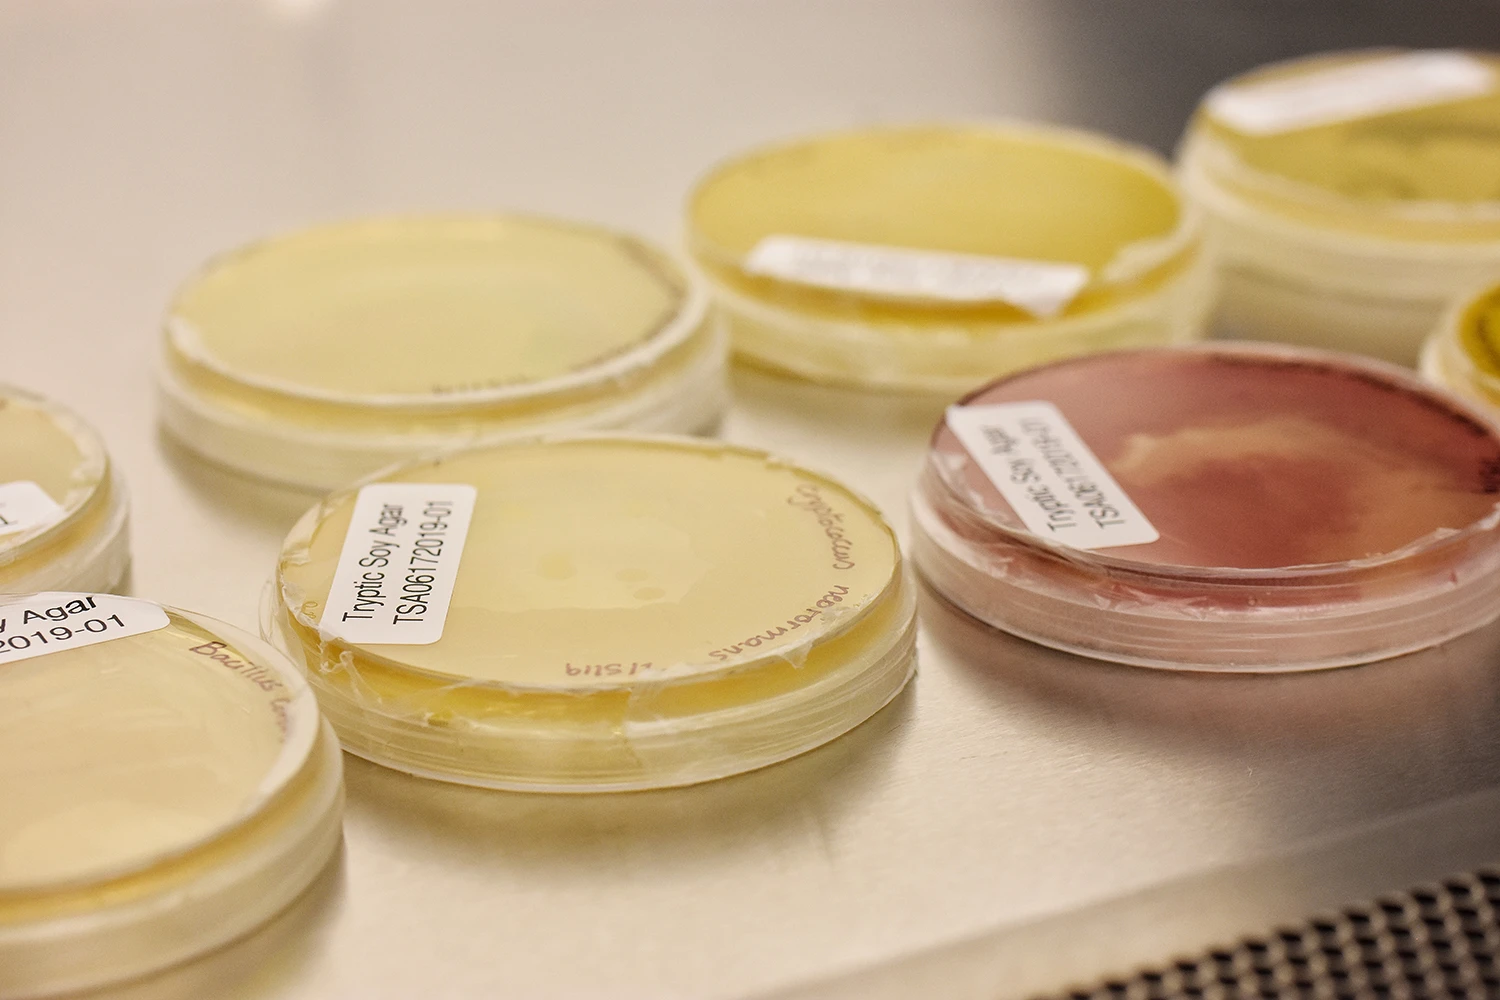
APRC's Microlab

APRC's Microlab
Apr 5, 2024 📙 1 min read
APRC is constantly evolving and growing as the premiere third-party laboratory specializing in aromatic plants. Our primary lab has microbial capabilities to accommodate testing at biosafety level two. Our board member Dr. Noura Dosoky has set up this lab to test for bacteria and fungi, such as E. coli, Pseudomonas aeruginosa, Staphylococcus aureus, salmonella, Candida albicans, and more.
Dishes in the Microlab
Research in this lab includes finding the effects of essential oils and natural products on the growth of various microorganisms. Our clients also hire us to do microbial screening of their products. While a majority of essential oils have antimicrobial properties, carrier oils and other products are more susceptible to microbial growth. This can lead to contamination of a product if processing is done incorrectly or the packaging is not sterile before bottling.
The process for microbial screening requires a standard plate with a 4-way streak method and the sample plate with a pour method. If a sample has a preservative, they are incubated overnight in a broth culture called enrichment broth. The standard plate is wiped with the standard organism in four different directions, which dilutes the organism by the fourth side. This allows Dr. Dosoky to see individual organism colonies on the diluted side.

The Streak Method
The pour method on the sample plate pours the liquid sample onto the gel, which is then flipped over, allowing the oil to spread and remain in place on the bottom of the plate. Both the standard and the sample plates are left to grow organisms. If the sample grows more than 300 colonies, it is contaminated.

Fungi Grown Using the Pour Method





